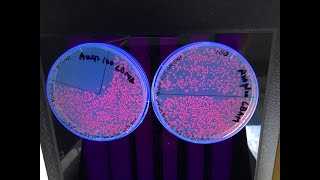

How to do a CaCl2 transformation buffer (Transformation part 1) video
Online izle ve mp4 mp3 formatlarinda yukle
Videonun muddeti: 12:56
How to do a CaCl2 transformation buffer (Transformation part 1) videosu mp4 ve mp3 yuklemek ucun hazirdir
Diqqet! Siz Mp4 yukle ve ya Mp3 yukle duymesine basdiqdan sonra eger sistem sizi reklam sehifesine atarsa o zaman derhal geri qayidib emeliyyati tekrar edin ve faylin yuklemek ucun hazir olmasini gozleyin
Videodan Mp4 Yukle
Videodan Mp3 Yukle-1
Videodan Mp3 Yukle-2
Oxshar Axtarishlar
How to do a CaCl2 transformation buffer (Transformation part 1)
Heat-Shock Transformation Protocol (for Bacteria)
Bacterial Transformation
Preparation of Competent Cells Using Calcium Chloride - Amrita University
Competent Cells: CaCl2 Transformation Technique| Role of CaCl2 in Competent Cells Preparation
The Mechanism of Transformation with Competent Cells
Bacterial Transformations
CaCl2 Transformation Method | Heat Shock Transformation | Preparation Of Competent Cells Using CaCl2
DNA Transformation | Calcium Chloride method of transformation
Video Mp4 Mp3Azwap.Biz
Azwap.Biz 2021-2023